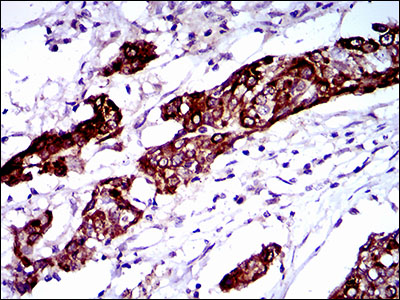

BRCA1 Mouse Monoclonal Antibody(ARA861)
CAT.NO. : ARA6687
RMB Please choose
RMB Please choose
Size:
Trail, Bulk size or Custom requests Please contact us
*产品价格可能会有所调整,请以品牌方官网实时更新的价格为准,以确保准确性。
Background
BRCA1 (breast and ovarian cancer susceptibility protein 1) is a nuclear phosphoprotein that plays a role in maintaining genomic stability and acts as a tumor suppressor in combination with other tumor suppressors, DNA damage sensors, and signal transducers to form a large multi-subunit protein complex known as BASC (for BRCA1 associated genome surveillance complex). BRCA1 associates with RNA polymerase II, and through the C terminal domain, also interacts with histone deacetylase complex. The BRCA1 protein thus plays a role in transcription, DNA repair of double-stranded breaks, and recombination. Mutations in the BRCA1 gene are responsible for approximately 40% of inherited breast cancers and more than 80% of inherited breast and ovarian cancers. Alternative splicing plays a role in modulating the subcellular localization and physiological function of this gene. Many alternatively spliced transcript variants, some of which are disease-associated mutations, have been described for this gene, but the full-length natures of only some of these variants has been described. A related pseudogene, which is also located on chromosome 17, has been identified.
Application
Application |
Dilution Ratio |
IHC-P |
1:100-1:500 |
Overview
Antibody Type |
Mouse Monoclonal Antibody |
Immunogen |
Recombinant protein |
Species Reactivity |
Human |
Molecular Weight |
208 kDa |
Positive Control |
Human BRCA1 recombinant protein, BRCA1-hIgGFc transfected HEK293 cell lysate, human esophagus cancer tissue, human esophagus tissue |
Conjugation |
unconjugated |
Form |
Liquid |
Storage Buffer |
Purified antibody in PBS with 0.05% sodium azide |
Isotype |
IgG1 |
Purification Method |
Protein A affinity purified |
Data
Immunohistochemical analysis of paraffin-embedded human esophagus cancer tissue using BRCA1 Mouse Monoclonal Antibody(ARA861).

Immunohistochemical analysis of paraffin-embedded human esophagus tissue using BRCA1 Mouse Monoclonal Antibody(ARA861).
Storage
Store at 4°C short term. For long term storage, store at -20°C, avoiding freeze/thaw cycles.
Research Use Only
For Research Use Only. Not for use in diagnostic procedures.
